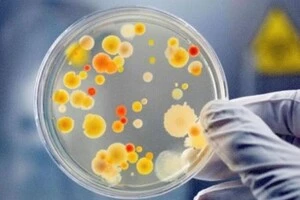

кишкова інфекція

Епідеміологи перевіряють продукти, воду та поверхні у дитсадку №183.
8 травня, 04:19

Станом на 29 березня до лікарні потрапили вісім дошкільнят
29 березня, 18:39

Джерело інфекції та фактори передачі наразі встановлюються
24 лютого, 04:46

Всі постраждалі харчувалися в їдальні одного з львівських ліцеїв, їхній стан середньої важкості
7 листопада, 2025 19:13

МОЗ повідомляє про спалахи гострих кишкових інфекцій у трьох областях України
22 липня, 2025 13:44
Фахівці розпочали епідеміологічне розслідування з метою встановлення джерела та причин виникнення спалаху інфекції
20 травня, 2025 10:24

У шести пацієнтів, які контактували з хворими, не було ознак хвороби, але аналізи показали наявність вірусу
18 грудня, 2024 20:29

Гострі кишкові інфекції у дітей можуть призвести до серйозних ускладнень
17 вересня, 2024 20:22

Всі хворі школярі були бактеріологічно обстежені на кишкову групу інфекцій
9 вересня, 2024 13:27

Розпочато позаплановий захід державного контролю потужності, яка постачала продукти у готель, де жили діти
17 червня, 2024 23:15

На стаціонарному лікуванні станом на 1 вересня перебувають 17 малюків
1 вересня, 2023 21:54

Серед постраждалих – двоє дітей
13 червня, 2023 16:52

Госпіталізовано 11 осіб, серед них дев’ятеро дітей
6 березня, 2023 00:30

Київський міський центр контролю та профілактики хвороб розпочав розслідування
21 червня, 2022 12:57

В однієї людини лабораторно виділена Salmonella enteritidis
19 червня, 2022 05:31

Усім хворим встановлено діагноз гостра кишкова інфекція
18 червня, 2022 04:23

Covid-19 до осені повернеться до України, але катастрофічної ситуації уже не буде
6 червня, 2022 13:58

Виявлені носії інфекцій будуть відсторонені від роботи на час лікування й до повного одужання
20 жовтня, 2021 18:33

Усі хворі діти обстежені «швидкими» тестами на ротавіруси
24 вересня, 2021 14:14

«Вакцинувати треба дорослих, тоді діти хворітимуть менше»
23 вересня, 2021 16:05

Школу в Попівці зачинили, діти навчаються дистанційно
17 вересня, 2021 20:59

Поліція почала перевірку обставин отруєння малюків
16 вересня, 2021 21:35

Батьки, які привели сьогодні школярів на заняття, за здоров’я дітей не хвилюються
6 вересня, 2021 16:44

Почастішали симптоми гастроентериту, наприклад, блювота, нудота, болі в животі і діарея
26 серпня, 2021 13:19

Недужих із попереднім діагнозом «гостра кишкова інфекція» госпіталізували до Богородчанської центральної районної лікарні
21 червня, 2021 09:41

Двоє дітей перебувають на стаціонарному лікуванні та сім дітей лікуються амбулаторно
22 лютого, 2021 08:40

Зокрема, спільними продуктами харчування для всіх потерпілих були салат «Дружба» та бульйон
28 вересня, 2020 15:44

З 24 по 27 вересня до лікувальних закладів звернулося 194 особи (за добу 6 осіб), з яких 59 осіб госпіталізовано
28 вересня, 2020 08:28

Проводиться комплекс протиепідемічних та санітарно-гігієнічних заходів
26 вересня, 2020 09:46

Профілактика і правила консервування
17 липня, 2020 13:52
